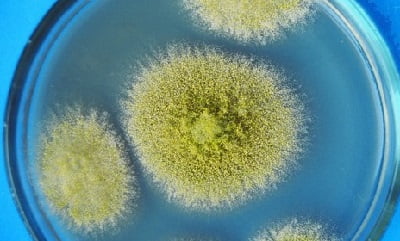

Аспергиллез — симптомы у человека, диагностика и лечение
Аспергиллез — заболевание, которое вызывается грибками семейства Aspergillus и характеризуется поражением различных органов и систем организма, однако чаще всего страдает бронхолегочная система.
Болезнь протекает, как правило, хронически с различными аллергическими реакциями или токсическими проявлениями. Возбудитель аспергиллеза достаточно сильно распространен в окружающей среде — они есть и в земле, и в воде, и в воздухе, способен размножаться и в человеческом организме, и у животных.
В связи с тем, что первый удар принимает респираторная система, то главные симптомы аспергиллеза начинают проявляться как раз со стороны органов дыхания. Иногда грибок попадает в организм с кровью и лимфой, быстро распространяясь по всем органам. Такой тип заболевания характеризуется высоким уровнем летальности — около 80%.
Что это такое?
Аспергиллез — это микоз, вызываемый некоторыми видами плесневых грибков типа Aspergillus. Аспергиллез протекает с множественными хроническими токсико-аллергическими проявлениями.
Если человек заболевает аспергиллезом, то чаще всего он подвергается заражению бронхолегочной системы и придаточных пазух. В некоторых случаях аспергиллез влияет на кожу, зрительную и центральную нервную систему.
Врачи отмечают, что аспергиллез представляет собой серьезную грибковую инфекцию, вызываемую грибами рода Aspergillus. Эта болезнь чаще всего затрагивает легкие, но может также поражать другие органы, особенно у пациентов с ослабленным иммунитетом. Специалисты подчеркивают важность ранней диагностики, так как симптомы могут быть не специфичными и напоминать другие заболевания дыхательных путей. Лечение аспергиллеза требует комплексного подхода, включая противогрибковые препараты и, в некоторых случаях, хирургическое вмешательство. Врачи также акцентируют внимание на профилактике, особенно среди людей с высоким риском, таких как пациенты с онкологическими заболеваниями или после трансплантации органов. Образование и информирование населения о возможных источниках инфекции, таких как плесень в помещениях, играют ключевую роль в снижении заболеваемости.
https://youtube.com/watch?v=HXUWxr8HuqI
Причины аспергиллёза
Возбудители болезни принадлежат к роду Aspergillus, а в патологии человека наибольшее значение имеют A. Flavus и A. Niger, но могут встречаться и другие виды, например, A. Nidulans или A. Fumigatus. Можно сказать, что морфологически такие виды грибов состоят из однотипного мицелия, имеющего ширину 4-6 мкм. Аспергиллы, как правило, обладают достаточно большой биохимической активностью, благодаря чему могут образовывать различные ферменты.
Возбудители аспергиллёза легких имеют широкое распространение в природе. Чаще всего их можно обнаружить в сене, муке, почве и зерне, а также в пыли. В организм возбудитель обычно попадает с пылью через воздух. Аэрогенным путём он попадает на слизистые оболочки, расположенные на верхних дыхательных путях. Вполне возможно инфицирование и через кожу, которая зачастую изменяется иным патологическим процессом.
Снижение иммунной защиты организма играет ведущую роль в развитии аспергиллёза. Данная болезнь может быть осложнена различными патологическими процессами кожи, внутренних органов и слизистых оболочек.
Классификация
Аспергиллез различается по локализации своих патологических процессов:
- бронхолегочный (в том числе аспергиллез легких);
- аспергиллез лор-органов;
- аспергиллез кожи, глаз и костей;
- септический, или генерализованный аспергиллез.
В зависимости от путей инфицирования грибками, различают несколько видов аспергиллеза:
- эндогенный (аутоинфекция);
- экзогенный (воздушно-капельный или алиментарный путь передачи);
- трансплацентарный (вертикальный пути заражения);
Согласно статистике, примерно 90 процентов всех случаев заболевания аспергиллезом приходится на первичное заражение респираторного тракта, а также легких. Около пяти процентов — на заражение придаточных пазух носа. Кроме того, вовлечение в патологический процесс других человеческих органов диагностируется почти у пяти процентов людей, подверженных инфицированию.
Аспергиллез — это грибковая инфекция, вызываемая грибами рода Aspergillus, и мнения о ней среди людей варьируются. Многие пациенты, столкнувшиеся с этой болезнью, отмечают, что симптомы могут быть очень разнообразными: от легкого кашля до серьезных проблем с дыханием. Некоторые делятся опытом длительного лечения и трудностями, связанными с диагностикой, так как симптомы часто напоминают другие заболевания. В то же время, врачи подчеркивают важность раннего выявления и лечения, чтобы избежать осложнений. Люди, имеющие ослабленный иммунитет, особенно уязвимы, и их истории часто служат предупреждением о необходимости заботиться о здоровье. В социальных сетях можно встретить множество обсуждений, где пациенты обмениваются советами и поддержкой, что помогает справляться с заболеванием и не терять надежду на выздоровление.
https://youtube.com/watch?v=jjhsCesKQZk
Аспергиллез легких
Аспергиллез легких является очень серьезным диагнозом. Так как из-за развития заболевания, которое вызвали плесневые грибы-аспергиллы, в легких человека начинают формироваться аспергилломы, то есть опухолевидные образования, которые состоят из плотно сплетенных грибков. Еще встречаются и такие осложнения, как эндокардиты, аспергиллезные плевриты, отиты, менингоэнцефалиты и другие.
Однако в любой момент аспергиллома может вызвать грозное осложнение — это легочное кровотечение, которое может быть массивным и профузным. И в этом случае альтернатива хирургического лечения отсутствует. Лечение аспергиллеза консервативными методами возможно при поражениях грибком слизистых оболочек или кожи.
Симптомы аспергиллеза у человека
Поскольку первый удар на себя принимает респираторная система, то основные симптомы аспергиллеза у человека начинают проявляться именно со стороны органов дыхания. В трети случаев грибок проникает в организм с током крови и лимфы и разносится по всем органам. При таком типе аспергиллеза высокая летальность — около восьмидесяти процентов. Наиболее редкий — кожный аспергиллез.
Если грибок обосновался на поверхности и не проник в слизистую, как это бывает при трахеобронхите, аспергилломе, то больные отмечают у себя следующие симптомы: хронический кашель с отделением мокроты, иногда с кровью при натужном кашле. Чаще всего в таких случаях есть патологии со стороны легких.
В ответ на проникновение спор организм ткани человека вырабатывают определенные воспалительные реакции. Наиболее распространены два типа воспалений — серозно-десквамативное и фиброзно-гнойное. При серозно-десквамативном воспалении аспергилла вызывает отшелушивание эпителия, оболочек желудка, легких с выделением экссудата (плазмы с элементами крови). При втором типе — фиброзно-гнойном — аспергилла вызывает выделение экссудата с фибрином (свернувшимся белком крови) и гнойным компонентом. Наиболее тяжелая реакция на аспергиллез — образование гранулем в легких.
В ином случае аспергиллез дает острую картину — в легких образуется плотный инфильтрат, который распадается. С током крови происходит инфицирование и других органов. При начале острого аспергиллеза характерно явление нейтропении, которое выражается во внезапной слабости, носовом кровотечении, повышении температуры, резком ознобе, сильном выпотевании, тахикардии, резком понижении давления. В этом случае в крови обнаруживается снижение нейтрофилов, которые затрудняют организму давать воспалительный ответ на очаг аспергиллеза. Поэтому при нейтропении диагностировать аспергиллез часто не удается — все показатели казалось бы в норме. Однако по опыту врачи знают, что это может сигнализировать о начинающемся аспергиллезе, поэтому назначаются дополнительные исследования. Чаще всего аспергиллы поселяются на пазухах носа. При этом появляются красные очаги, после распада тканей они теряют свою окраску, а потом чернеют. Этот процесс очень стремителен — обычно перекидывается на глазницы, ткани лица, в сторону головного мозга. Типичные симптомы в этом состоянии — заложенность, боль в области носоглотки, носовых пазух, распухание слизистой оболочки. Пазухи наполнены гноем, но они не прорываются.
Часто аллергический аспергиллез присоединяется к бронхиальной астме. При этом пациенты отмечают астматические приступы, в крови увеличены эозинофилы, темные области на рентгеновском исследовании, наличие антител в сыворотке (галактоман). Для уточнения диагноза берется анализ мокроты. У более чем половины больных при посеве обнаруживают аспергиллу. В этом случае делают вторичный посев для уточнения диагноза (поскольку конидии могли и случайно попасть).
https://youtube.com/watch?v=RIdD45twYk8
Диагностика
Аспергиллез у взрослых требует тщательной и комплексной диагностики, которая, прежде всего, необходима для выявления разновидности и степени тяжести протекания такой болезни.
Первым этапом установления правильного диагноза занимается тот клиницист, к которому обратился человек, основываясь на преобладающем симптоме. Врачу необходимо:
- ознакомиться с историей болезни и анамнезом жизни пациента — это может указать на некоторые этиологические факторы;
- провести детальный опрос пациента — для выяснения первого времени появления и степени интенсивности выражения симптоматики. Это даст возможность определить клиницисту тяжесть течения болезни;
- выполнить тщательный физикальный осмотр, который в зависимости от ситуации может включать в себя офтальмологический осмотр глаз, пальпацию передней стенки брюшной полости, изучение состояния кожного покрова и ногтевых пластин, а также прослушивание лёгких при помощи фонендоскопа.
Инструментальная диагностика аспергиллеза включает в себя осуществление:
- рентгенографии грудной клетки;
- биопсии;
- бронхоскопии;
- спирометрии;
- КТ.
Лабораторные обследования также будут отличаться в зависимости от характера протекания инфекции. В большинстве случаев, они включают в себя:
- изучение отделяемого из носовых пазух или наружного слухового прохода;
- микроскопическое исследование каловых масс;
- общий анализ крови — может указать на протекание аллергического или воспалительного процесса;
- анализ мокроты, выделяемой при кашле — для выявления частичек аспергилл;
- биохимию крови;
- соскоб с кожного покрова или ногтевых пластин;
- отпечаток с поверхности роговицы;
- ПЦР.
Подобные мероприятия помогут не только поставить правильный диагноз, но и провести дифференциальную диагностику подобного недуга.
Лечение аспергиллеза
Вне зависимости от типа аспергиллеза у человека, лечение является весьма трудоемкой задачей. Химиотерапия и антибактериальные средства не приводят к ожидаемому эффекту, как, впрочем, и все остальные известные врачам методики борьбы с инфекционными заболеваниями.
По этой причине в последние годы при постановке диагноза аспергиллез, лечение строится на использовании хирургических методов. Больным проводится лобэктомия с резекцией пораженных органов. Если операция проводилось компетентным специалистом с соблюдением всех установленных процедур — вмешательство переносится без осложнений и дает хорошие прогнозы на будущее.
При запущенных формах аспергиллеза легких хирургическое лечение используется совместно с консервативными методами. Больным аспергиллезом назначают амфотерицин В, оксациллин, нистатин, эритромицин, антибиотики тетрациклиновой группы. Одновременно с этим человек принимает витамины. Также больным аспергиллезом рекомендовано общеукрепляющее лечение.
При использовании антимикотических препаратов количество антител в крови резко возрастает, но к концу лечения оно приходит в норму. Если аспергиллез легких приводит к поражениям кожи и слизистых оболочек, больным рекомендованы противомикозные и противовоспалительные средства.
Прогноз и профилактика
Наиболее благоприятное течение отмечается при аспергиллезе кожи и слизистых оболочек. Летальность от легочных форм микоза составляет 20-35%, а у лиц с иммунодефицитом — до 50%. Септическая форма аспергиллеза имеет неблагоприятный прогноз.
К мерам, позволяющим предупредить заражение аспергиллезом, относятся мероприятия по улучшению санитарно-гигиенических условий: борьба с пылью на производстве, ношение работниками мельниц, зернохранилищ, овощехранилищ, ткацких предприятий индивидуальных средств защиты (респираторов), улучшение вентиляции цехов и складов, регулярное микологическое обследование лиц из групп риска.
Вопрос-ответ
Как можно заразиться аспергиллами?
Механизм развития аспергиллёза. В организм аспергиллы, как правило, попадают воздушно-пылевым путём: человек вдыхает частицы пыли, которые содержат споры этих грибков. Также заразиться можно от домашних птиц, например, кур-несушек, бройлеров, голубей, гусей, индеек.
Сколько живут с аспергиллезом?
Таким образом, около трети пациентов с хроническим легочным аспергиллезом умирают в течение 5 лет от момента выявления заболевания.
Что убивает Аспергилл?
Грибы рода Aspergillus склонны поражать открытые места, такие как полости в легких, что вызвано предыдущими заболеваниями легких (например, расширение бронхов, опухоль, туберкулез), пазухи или наружные слуховые проходы (отомикоз).
Советы
СОВЕТ №1
Обратите внимание на симптомы. Аспергиллез может проявляться различными симптомами, такими как кашель, одышка, боль в груди и лихорадка. Если вы заметили у себя или близких подобные признаки, особенно если у вас есть предрасположенность к заболеваниям легких, обратитесь к врачу для диагностики.
СОВЕТ №2
Избегайте контакта с потенциальными источниками спор. Аспергиллез вызывается грибами рода Aspergillus, которые могут находиться в пыли, гниющих растениях и других органических материалах. Старайтесь избегать работы в местах с высокой концентрацией пыли и грибков, особенно если у вас ослабленный иммунитет.
СОВЕТ №3
Поддерживайте здоровье иммунной системы. Правильное питание, регулярные физические нагрузки и достаточный сон помогут укрепить вашу иммунную систему, что снизит риск развития аспергиллеза и других инфекционных заболеваний.
СОВЕТ №4
Следите за чистотой в доме. Регулярная уборка и проветривание помещений помогут уменьшить количество спор грибов в воздухе. Используйте воздухоочистители и поддерживайте оптимальную влажность в помещениях, чтобы предотвратить рост грибков.